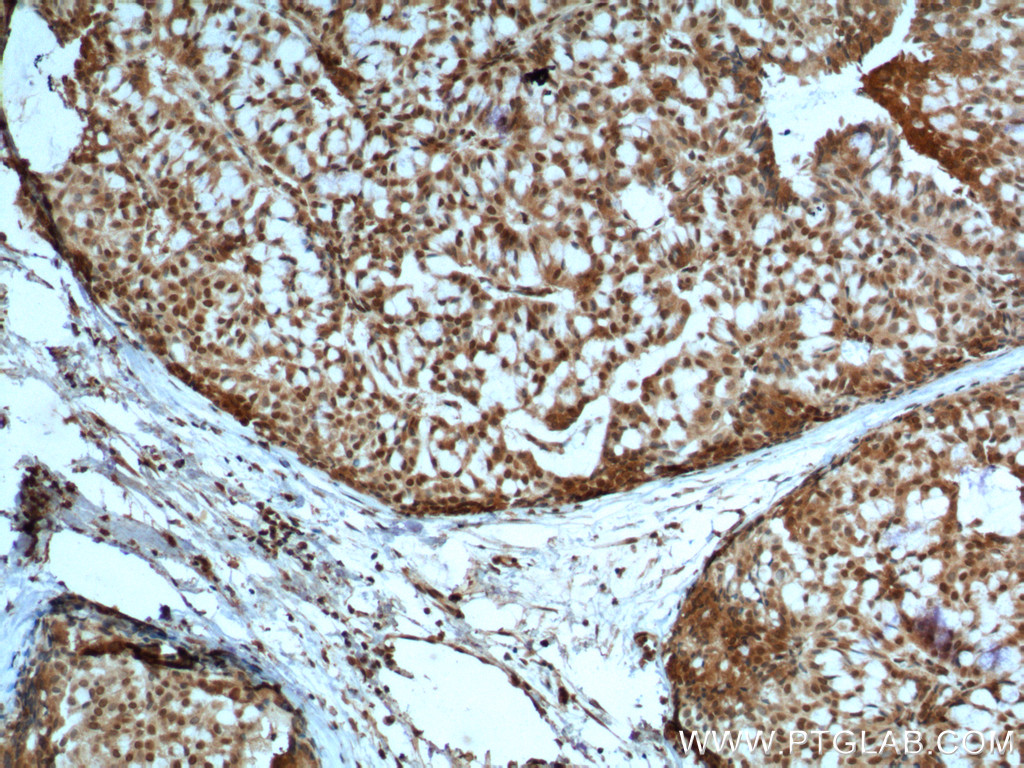
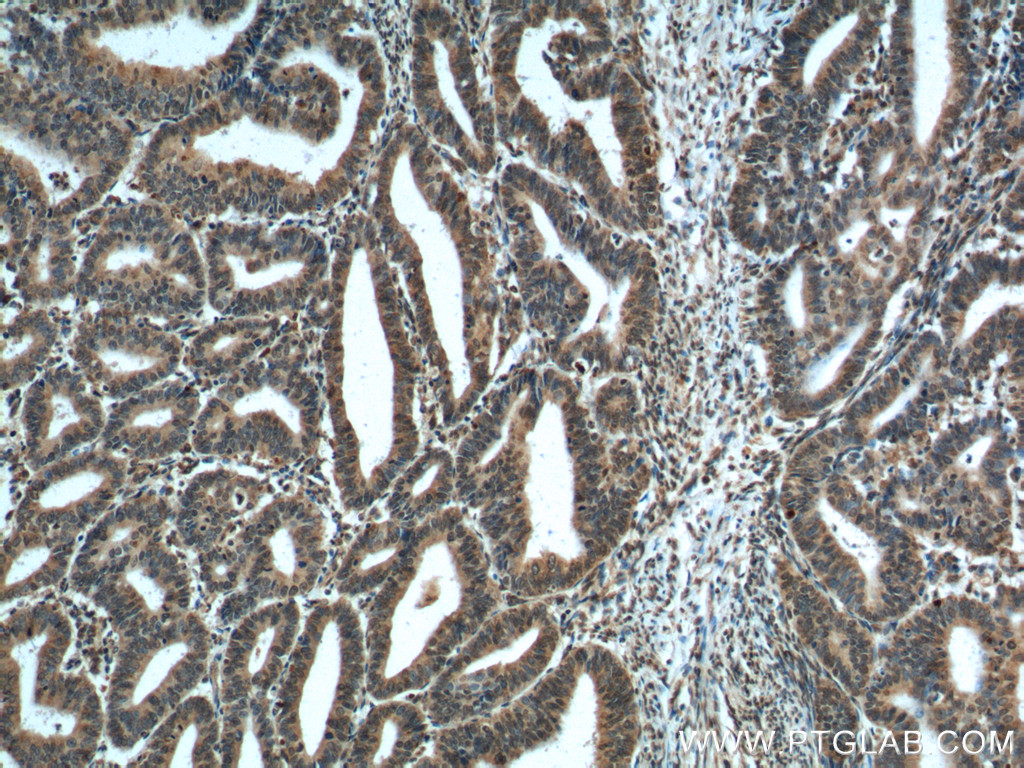
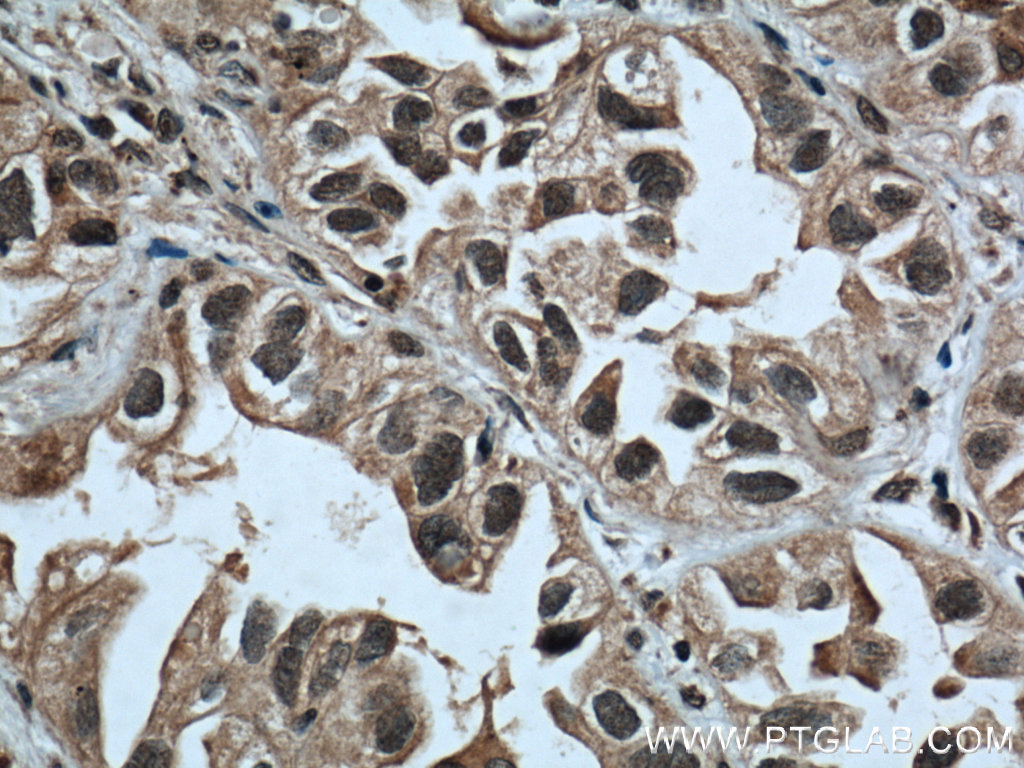

验证数据展示
经过测试的应用
| Positive WB detected in | DU 145 cells, fetal human brain tissue, HeLa cells, HEK-293 cells, MCF-7 cells, NIH/3T3 cells, HepG2 cells |
| Positive IHC detected in | human breast hyperplasia tissue, human breast cancer tissue, human endometrial cancer tissue, human lung cancer tissue, human prostate hyperplasia tissue Note: suggested antigen retrieval with TE buffer pH 9.0; (*) Alternatively, antigen retrieval may be performed with citrate buffer pH 6.0 |
| Positive IF/ICC detected in | HepG2 cells |
推荐稀释比
| 应用 | 推荐稀释比 |
|---|---|
| Western Blot (WB) | WB : 1:2000-1:10000 |
| Immunohistochemistry (IHC) | IHC : 1:200-1:1200 |
| Immunofluorescence (IF)/ICC | IF/ICC : 1:200-1:800 |
| It is recommended that this reagent should be titrated in each testing system to obtain optimal results. | |
| Sample-dependent, Check data in validation data gallery. | |
产品信息
60300-1-Ig targets PTEN in WB, IHC, IF/ICC, IP, ELISA applications and shows reactivity with human, mouse samples.
| 经测试应用 | WB, IHC, IF/ICC, ELISA Application Description |
| 文献引用应用 | WB, IHC, IF, IP |
| 经测试反应性 | human, mouse |
| 文献引用反应性 | human, mouse |
| 免疫原 |
CatNo: Ag17274 Product name: Recombinant human PTEN protein Source: e coli.-derived, PGEX-4T Tag: GST Domain: 204-403 aa of BC005821 Sequence: PMFSGGTCNPQFVVCQLKVKIYSSNSGPTRREDKFMYFEFPQPLPVCGDIKVEFFHKQNKMLKKDKMFHFWVNTFFIPGPEETSEKVENGSLCDQEIDSICSIERADNDKEYLVLTLTKNDLDKANKDKANRYFSPNFKVKLYFTKTVEEPSNPEASSSTSVTPDVSDNEPDHYRYSDTTDSDPENEPFDEDQHTQITK 种属同源性预测 |
| 宿主/亚型 | Mouse / IgG2a |
| 抗体类别 | Monoclonal |
| 产品类型 | Antibody |
| 全称 | phosphatase and tensin homolog |
| 别名 | 10q23del, 5C10B6, Bannayan Zonana syndrome, BC005821, BZS |
| 计算分子量 | 47 kDa |
| 观测分子量 | 55 kDa |
| GenBank蛋白编号 | BC005821 |
| 基因名称 | PTEN |
| Gene ID (NCBI) | 5728 |
| RRID | AB_2881415 |
| 偶联类型 | Unconjugated |
| 形式 | Liquid |
| 纯化方式 | Protein A purification |
| UNIPROT ID | P60484 |
| 储存缓冲液 | PBS with 0.02% sodium azide and 50% glycerol, pH 7.3. |
| 储存条件 | Store at -20°C. Stable for one year after shipment. Aliquoting is unnecessary for -20oC storage. |
背景介绍
PTEN (also designated MMAC1), products of tumor suppressor genes, are found deleted in most human gliomas. The PTEN genes are also mutated in many other tumors, such as brain, breast, kidney and prostate cancers. PTEN is a protein tyrosine phosphatase that may terminate the signaling transduction pathways mediated by PI 3-kinase/Akt. PTEN has an apparent molecular weight of 55 kDa.
实验方案
| Product Specific Protocols | |
|---|---|
| IF protocol for PTEN antibody 60300-1-Ig | Download protocol |
| IHC protocol for PTEN antibody 60300-1-Ig | Download protocol |
| WB protocol for PTEN antibody 60300-1-Ig | Download protocol |
| Standard Protocols | |
|---|---|
| Click here to view our Standard Protocols |
发表文章
| Species | Application | Title |
|---|---|---|
Mol Cell Fumarate inhibits PTEN to promote tumorigenesis and therapeutic resistance of type2 papillary renal cell carcinoma. | ||
J Hazard Mater Exposure to 6PPD-Q induces dysfunctions of ovarian granulosa cells: Its potential role in PCOS | ||
Hepatology Long noncoding RNA TSLNC8 is a tumor suppressor that inactivates the interleukin-6/STAT3 signaling pathway. | ||
Hepatology Cyclin G1-mediated epithelial-mesenchymal transition via phosphoinositide 3-kinase/Akt signaling facilitates liver cancer progression. | ||
Cancer Res Targeting USP7 identifies a metastasis-competent state within bone marrow-resident melanoma CTCs. |